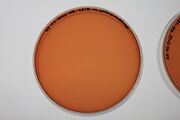

Uploads by Howard Boland
From OpenWetWare
Jump to navigationJump to search
This special page shows all uploaded files.
| Date | Name | Thumbnail | Size | Description |
|---|---|---|---|---|
| 18:03, 18 February 2011 | 16-feb-2011-pSB1A3-E-P.jpg (file) |  |
64 KB | |
| 16:21, 18 February 2011 | 17feb2011-LBEPBSXB.jpg (file) |  |
66 KB | |
| 19:45, 15 February 2011 | 15-FEB-2011-j04450.jpg (file) |  |
54 KB | |
| 19:12, 11 February 2011 | 10-feb-2011-backbone-digests.jpg (file) |  |
57 KB | |
| 18:33, 5 February 2011 | 04022011-backbone.jpg (file) |  |
45 KB | |
| 23:09, 3 February 2011 | 03022011-ALL-DIGEST-PURIFIED.jpg (file) |  |
50 KB | |
| 19:19, 3 February 2011 | 03022011-double-digest.jpg (file) |  |
43 KB | |
| 17:47, 2 February 2011 | 02022011-double digests.jpg (file) |  |
50 KB | |
| 12:13, 31 January 2011 | 08 Schuler.jpg (file) |  |
45 KB | |
| 12:02, 31 January 2011 | 28012011-pcr-bba kate.jpg (file) |  |
71 KB | |
| 10:28, 31 January 2011 | Fsm-broth-no-growth-28.jpg (file) |  |
57 KB | |
| 10:28, 31 January 2011 | Iron-agarplate-no-growth-28.jpg (file) | |
52 KB | |
| 10:15, 31 January 2011 | Bruscella-broth-prepared.jpg (file) |  |
56 KB | |
| 10:12, 31 January 2011 | Fsm-200ml-prepared.jpg (file) |  |
86 KB | |
| 10:12, 31 January 2011 | Fsm-10ml-prepared.jpg (file) |  |
65 KB | |
| 10:12, 31 January 2011 | Ferric-citrate-prepared.jpg (file) |  |
48 KB | |
| 10:09, 31 January 2011 | Iron-agar-prepared.jpg (file) |  |
85 KB | |
| 14:06, 24 November 2010 | 24112010-pSense66-X-B-2.jpg (file) |  |
45 KB | |
| 22:34, 23 November 2010 | 22112010-dishtest.jpg (file) |  |
106 KB | |
| 22:30, 23 November 2010 | 18112010-psti--xhoi-bamhi-darker.jpg (file) |  |
45 KB | |
| 22:19, 23 November 2010 | 19112010-plasmids-and-cuts.jpg (file) |  |
63 KB | |
| 22:08, 23 November 2010 | 23112010-multi.jpg (file) |  |
69 KB | |
| 22:04, 23 November 2010 | 23112010-dishtest.jpg (file) |  |
47 KB | |
| 18:47, 23 November 2010 | 22112010-pUA66katE-PstI.jpg (file) |  |
48 KB | |
| 18:47, 23 November 2010 | 22112010-pSense66-Digests.jpg (file) |  |
45 KB | |
| 21:37, 15 November 2010 | 15112010-pcr-digested-psti.jpg (file) |  |
53 KB | |
| 21:32, 15 November 2010 | 15112010-pcr-result.jpg (file) |  |
51 KB | |
| 13:51, 12 November 2010 | 11112010-psense66-transformed-ligation-test.jpg (file) |  |
52 KB | |
| 13:45, 12 November 2010 | 06112010-one-colony.jpg (file) |  |
40 KB | |
| 19:32, 6 November 2010 | 06112010-petridishes.jpg (file) |  |
44 KB | |
| 19:26, 6 November 2010 | 06112010-pcr-gelcut-psense66.jpg (file) |  |
59 KB | |
| 09:08, 5 November 2010 | 04112010-2.jpg (file) |  |
49 KB | |
| 11:45, 4 November 2010 | 03102010-pcr2300bp.jpg (file) |  |
56 KB | |
| 14:18, 3 November 2010 | 31112010-pcr-andother.jpg (file) |  |
54 KB | |
| 14:02, 3 November 2010 | 30102010-pcr-product-790-gel-cut.jpg (file) |  |
47 KB | |
| 14:02, 3 November 2010 | 30102010-pcr-2300-porduct-noproduct.jpg (file) |  |
46 KB | |
| 14:02, 3 November 2010 | 01112010-pcr-andother.jpg (file) |  |
54 KB | |
| 19:00, 29 October 2010 | 29102010-pcr-product-pSense66-noproduct.jpg (file) |  |
49 KB | |
| 15:47, 28 October 2010 | 27102010-2prcnt-gel-pBR322-pcr.jpg (file) |  |
52 KB | |
| 15:47, 28 October 2010 | 27102010-1prcnt-gel-pSense66-pcr.jpg (file) |  |
51 KB | |
| 15:41, 26 October 2010 | 26102010-2prcent.jpg (file) |  |
57 KB | |
| 15:41, 26 October 2010 | 26102010-1prcent.jpg (file) |  |
54 KB | |
| 15:23, 26 October 2010 | 25102010-1PRCNT-GEL-PCR-DIGESTED-AND-UNDIGESTED.jpg (file) |  |
53 KB | |
| 15:09, 26 October 2010 | 25102010-CUT-1PRCNT-GEL-PMAK512.jpg (file) |  |
53 KB | |
| 14:57, 26 October 2010 | 25102010-cut-2prcnt-gel-pUA66katE.jpg (file) |  |
53 KB | |
| 08:23, 22 October 2010 | 19102010-gel-picture-raw.jpg (file) |  |
49 KB | |
| 16:15, 21 October 2010 | 19102010-pcr-gel-cut.jpg (file) |  |
52 KB | First PCR Trial of new primers |
| 10:04, 21 August 2010 | 20082010-Screening-pUA66katE.jpg (file) |  |
58 KB | |
| 08:59, 21 August 2010 | 19082010-pUA66katE-x-b.jpg (file) |  |
50 KB | |
| 08:45, 21 August 2010 | 19082010-67-X-B.jpg (file) |  |
39 KB |